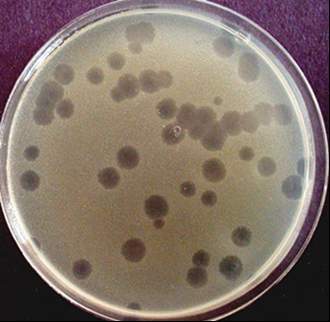

Мы приняли вашу заявку, свяжемся с вами в ближайшее время.

История
Часть товаров из корзины будет перемещена в статус отложенных и не сможет быть оформлена для заказа, если вы продолжите работу в данном регионе
История

История
История

|
Агары, бульоны, среды Becton Dickinson, Диаэм |

|

|

|

|

|
Среды SOB (Super Optimal Broth) и SOC (Super Optimal broth with Catabolic repressor) богаты питательными
веществами и применяются для выращивания компетентных клеток с последующей трансформацией; триптон обеспечивает азотом и углеродом, необходимыми для роста; дрожжевой экстракт является источником витаминов, в частности, группы В; ионы натрия и калия поддерживают необходимый осмос; сульфат магния является источником ионов магния, необходимых для работы бактериальных ферментов; глюкоза, входящая в состав среды SOC поставляет необходимый энергетический ресурс для восстановления клеток после трансформации и для репликации; в состав среды SOB глюкоза не входит. Расход: среда SOB - 28 г на 1 л; cреда SOC - 30 г на 1 л. |
|
Диаэм
Среда SOC |
|||||||||||||||||||||||||||
|
3133.0250
|
|||||||||||||||||||||||||||
|
|||||||||||||||||||||||||||
|
Диаэм
Среда SOB |
|||||||||||||||||||||||||||
|
3132.0250
|
|
250 г
|
|
По запросу По запросу |
|
|
|
||||||||||||||||||||
|
|||||||||||||||||||||||||||
|
244310
|
|
500 г
|
|
66 895, руб.
|
|
|
|
||||||||||||||||||||
|
Используется для выращивания рекомбинантных штаммов E.coli. Пептон и дрожжевой экстракт, входящие в состав среды, обеспечивают азотом и ростовыми факторами, что помогает бактериям лучше перенести стресс после трансформации и расти лучше.
Внешний вид светло-бежевый сыпучий гомогенный материал
Растворимость растворим в дистиллированной воде
Внешний вид 2,8%-ного раствора средне-бежевый
pH при 25°C 7,0
Примерный состав среды, г/л:
Триптон, г/л 20
Дрожжевой экстракт, г/л 5
Хлорид натрия, г/л 0,5
Сульфат магния, г/л 2,4
Хлорид калия, г/л 0,186
Условия хранения в сухом месте при комнатной температуре
Скачать брошюры: Техническое руководство BD Bionutrients, 3-е издание, англ., 72 стр., 3 MB |
|||||||||||||||||||||||||||
|
|
|||||||||||||||||||||||||||
Среды LB по Lennox и LB по Miller
|
Среды LB (Lisogenic Broth) используются для стандартных манипуляций с E.coli; LB по Miller
содержит 1% NaCl, LB по Lennox содержит 0,5% NaCl, среды с низкой концентрацией солей - для выращивания культур с солечувствительными антибиотиками; входящий в состав среды триптон служит источником азота и углерода; дрожжевой экстракт является источником витаминов, в частности, группы B и других метаболитов. |

|

|
|
3230
|
|
454 г
|
|
По запросу По запросу |
|
|
|
||||||||||||||||
|
|||||||||||||||||||||||
|
3135.0250
|
|||||||||||||||||||||||
|
|||||||||||||||||||||||
|
Диаэм
Бульон LB по Lennox |
|||||||||||||||||||||||
|
3134.0250
|
|||||||||||||||||||||||
|
|||||||||||||||||||||||
|
240230
|
|||||||||||||||||||||||
|
Используется для поддержания и роста рекомбинантных штаммов E.coli в молекулярной биологии. Среда обогащена аминокислотами, нуклеотидами, витаминами и другими метаболитами, которые синтезируют микроорганизмы, это позволяет E.coli расти быстрее, чем на траиционных средах. Внешний вид светло-бежевый сыпучий гомогенный материал Растворимость растворим в дистиллированной воде Внешний вид 2,0%-ного раствора светло-янтарный, слегка опалесцирующий pH при 25° C 7,0 Примерный состав среды, г/л: Триптон, г/л 10 Дрожжевой экстракт, г/л 5 Хлорид натрия, г/л 5 Условия хранения в сухом месте при комнатной температуреСкачать брошюру: Состав сред для исследовательских задач микробиологии и молекулярной генетики, брошюра, англ., 7 стр., 508 kB |
|||||||||||||||||||||||
|
|
|||||||||||||||||||||||

|

|
|
3144.0250
|
|||||||||||||||||||||||||
|
|||||||||||||||||||||||||
|
3145.0250
|
|||||||||||||||||||||||||
|
|||||||||||||||||||||||||
|
3143.0250
|
|||||||||||||||||||||||||
|
|||||||||||||||||||||||||
|
3142.0250
|
|||||||||||||||||||||||||
|
|||||||||||||||||||||||||
|
Диаэм
Агар LB по Miller |
|||||||||||||||||||||||||
|
3140.0250
|
|||||||||||||||||||||||||
|
|||||||||||||||||||||||||
|
Диаэм
Бульон L по Miller |
|||||||||||||||||||||||||
|
3141.0250
|
|||||||||||||||||||||||||
|
|||||||||||||||||||||||||
|
3138.0250
|
|||||||||||||||||||||||||
|
|||||||||||||||||||||||||
|
3137.0250
|
|||||||||||||||||||||||||
|
|||||||||||||||||||||||||
|
3136.0250
|
|||||||||||||||||||||||||
|
|||||||||||||||||||||||||
|
Диаэм
Агар LB по Lennox |
|||||||||||||||||||||||||
|
3139.0250
|
|||||||||||||||||||||||||
|
|||||||||||||||||||||||||
|
244620
|
|||||||||||||||||||||||||
|
Используется для поддержания и роста рекомбинантных штаммов E.coli в молекулярной биологии. Среда обогащена аминокислотами, нуклеотидами, витаминами и другими метаболитами, которые синтезируют микроорганизмы, это позволяет E.coli расти быстрее, чем на традиционных средах. Внешний вид светло-бежевый сыпучий гомогенный материал Растворимость растворим в дистиллированной воде Внешний вид 2,5%-ного раствора средне-бежевый, слегка опалесцирующий pH при 25°C 7,0 Примерный состав среды, г/л: Триптон, г/л 10 Дрожжевой экстракт, г/л 5 Хлорид натрия, г/л 10 Условия хранения в сухом месте при комнатной температуре |
|||||||||||||||||||||||||
|
244520
|
|||||||||||||||||||||||||
|
Используется для поддержания и роста рекомбинантных штаммов E.coli в молекулярной биологии. Среда обогащена аминокислотами, нуклеотидами, витаминами и другими метаболитами, которые синтезируют микроорганизмы, это позволяет E.coli расти быстрее, чем на традиционных средах. Внешний вид светло-бежевый сыпучий гомогенный материал Растворимость не растворяется в холодной воде, растворяется при кипячении в дистиллированной или деионизированной воде Внешний вид 4,0%-ного раствора средне-бежевый, слегка опалесцирующий pH при 25° C 7,0 Примерный состав среды, г/л: Триптон, г/л 10 Дрожжевой экстракт, г/л 5 Хлорид натрия, г/л 10 Агар, г/л 15 Условия хранения в сухом месте при комнатной температуреСкачать брошюру: Состав сред для исследовательских задач микробиологии и молекулярной генетики, брошюра, англ., 7 стр., 508 kB |
|||||||||||||||||||||||||
|
240110
|
|
500 г
|
|
РУ
Регистрационное удостоверение на медицинское изделие
Росздравнадзора
|
38 749, руб.
|
|
|
|
|||||||||||||||||
|
Используется для поддержания и роста рекомбинантных штаммов E.coli в молекулярной биологии. Среда обогащена аминокислотами, нуклеотидами, витаминами и другими метаболитами, которые синтезируют микроорганизмы, это позволяет E.coli расти быстрее, чем на традиционных средах. Внешний вид светло-бежевый сыпучий гомогенный материал Растворимость не растворяется в холодной воде, растворяется при кипячении в дистиллированной или деионизированной воде Внешний вид 3,5%-ного раствора средне-янтарный, слегка опалесцирующий pH при 25° C 7,0 Примерный состав среды, г/л: Триптон, г/л 10 Дрожжевой экстракт, г/л 5 Хлорид натрия, г/л 5 Агар, г/л 15 Условия хранения в сухом месте при комнатной температуреСкачать брошюру: Состав сред для исследовательских задач микробиологии и молекулярной генетики, брошюра, англ., 7 стр., 508 kB |
|||||||||||||||||||||||||
|
|
|||||||||||||||||||||||||
|
Среды Terrific богаты питательными веществами, необходимыми в логарифмической фазе роста рекомбинантных клеток E. coli; повышенное содержание триптона и дрожжевого экстракта в среде обеспечивают высокую плотность E.coli при нормальной аэрации; глицерин служит дополнительным источником энергии; фосфаты калия выполняют функцию буферных соединений для предотвращения снижения рН среды во время роста бактерий; применяется как альтернатива бульону LB при экспрессии рекомбинантных белков и наращивании плазмидной ДНК. Расход: бульон Terrific - 50 г на 1 л; среда на основе бульона Terrific с добавлением лактозы и глюкозы - 55 г на 1 л. |

|
|
3147.0250
|
|||||||||||||||||||||||
|
|||||||||||||||||||||||
|
3146.0250
|
|||||||||||||||||||||||
|
|||||||||||||||||||||||
|
243820
|
|||||||||||||||||||||||
|
Сильно обогащенная среда, разработанная для увеличения роста штаммов E.coli, трансфецированных плазмидами. Пептон и дрожжевой экстракт, входящие в состав среды, позволяют получить больший выход плазмид. Внешний вид светло-бежевый сыпучий гомогенный материал Растворимость растворим в дистиллированной воде Внешний вид 4,76%-ного раствора светло-бежевый pH при 25°C 7,2 Примерный состав среды, г/л: Казеиновый пептон (расщепленный ферментами поджелудочной железы), г/л 12,0 Дрожжевой экстракт, г/л 24,0 Гидрофосфат калия, г/л 9,4 Дигидрофосфат калия, г/л 2,2 Условия хранения в сухом месте при комнатной температуреСкачать брошюры: Техническое руководство BD Bionutrients, 3-е издание, англ., 72 стр., 3 MB |
|||||||||||||||||||||||
|
|
|||||||||||||||||||||||
Cреды YPD
|
3148.0250
|
|||||||||||||||||||||||
|
|||||||||||||||||||||||
|
242810
|
|
2 кг
|
|
По запросу По запросу |
|
|
|
||||||||||||||||
|
Используется для поддержания и размножения дрожжей; обогащена протеином и дрожжевым экстрактом, что обеспечивает более быстрый рост. Так, при экспоненциальном росте клетки делятся каждые 90 минут. Внешний вид светло-бежевый сыпучий гомогенный материал Растворимость растворим в дистиллированной воде Внешний вид 5,0%-ного раствора светло-бежевый, слегка опалесцирующий pH при 25°C 6,5 Примерный состав среды, г/л: Дрожжевой экстракт, г/л 10,0 Пептон, г/л 20,0 Декстроза, г/л 20,0 Агар, г/л 15,0 Условия хранения в сухом месте при комнатной температуреСкачать брошюру: Состав сред для исследовательских задач микробиологии и молекулярной генетики, брошюра, англ., 7 стр., 508 kB |
|||||||||||||||||||||||
|
242720
|
|
500 г
|
|
По запросу По запросу |
|
|
|
||||||||||||||||
|
Используется для поддержания и размножения дрожжей; обогащена протеином и дрожжевым экстрактом, что обеспечивает более быстрый рост. Так, при экспоненциальном росте клетки делятся каждые 90 минут. Внешний вид светло-бежевый сыпучий гомогенный материал Растворимость не растворяется в холодной воде, растворяется при кипячении в дистиллированной или деионизированной воде Внешний вид 6,5%-ного раствора светло-бежевый, слегка опалесцирующий pH при 25°C 6,5 Примерный состав среды, г/л: Дрожжевой экстракт, г/л 10,0 Пептон, г/л 20,0 Декстроза, г/л 20,0 Агар, г/л 15,0 Условия хранения в сухом месте при комнатной температуреСкачать брошюру: Состав сред для исследовательских задач микробиологии и молекулярной генетики, брошюра, англ., 7 стр., 508 kB |
|||||||||||||||||||||||
|
|
|||||||||||||||||||||||

|
Среды NZCYM (NZamine-Casaminoacid-YeastExtract-Magnesiumsulfate) для культивирования рекомбинантных штаммов E.coli и размножения фага лямбда; в состав сред
входят панкреатический гидролизат казеина, казаминовые кислоты, витамины и другие необходимые метаболиты, обеспечивающие быстрый рост биомассы; сульфат магния, входящий в состав среды служит источником ионов магния, способствующих протеканию различных ферментативных процессов в клетке, включающих репликацию ДНК. Расход: 22 г на 1 л. |
|
|
3149.0250
|
|||||||||||||||||||||||||
|
|||||||||||||||||||||||||
|
240410
|
|
500 г
|
|
По запросу По запросу |
|
|
|
||||||||||||||||||
|
Используется для выращивания рекомбинантных штаммов E.coli. Обогащенная среда NZCYM применяется для выращивания рекомбинантных штаммов E.coli и размножения фага λ. E.coli быстро растет на среде NZ, которая богата аминокислотами, витаминами и другими метаболитами. Внешний вид светло-бежевый сыпучий гомогенный материал Растворимость растворим в дистиллированной воде Внешний вид 2,2%-ного раствора светло-бежевый pH при 25°C 7,0 Примерный состав среды, г/л: Казеиновый пептон (расщепленный ферментами поджелудочной железы), г/л 10,0 Казаминовые кислоты, г/л 1,0 Дрожжевой экстракт, г/л 5,0 Хлорид натрия, г/л 5,0 Сульфат магния, г/л 0,98 Условия хранения в сухом месте при комнатной температуреСкачать брошюру: Состав сред для исследовательских задач микробиологии и молекулярной генетики, брошюра, англ., 7 стр., 508 kB |
|||||||||||||||||||||||||
|
|
|||||||||||||||||||||||||
|
Среды 2хYT (2хYeastextractand Tryptone) для роста рекомбинантной E.coli и размножения бактериофага 13М; богаты азотом и ростовыми факторами, что позволяет получать высокий титр фага без использования клетки-хозяина; входящие в состав аминокислоты и витамины способствуют быстрому росту рекомбинантных штаммов E.coli. Расход: 31 г на 1 л. |
|
244020
|
|
500 г
|
|
По запросу По запросу |
|
|
|
|||||
|
Разработана для роста рекомбинантных штаммов E.coli. Также используется для размножения фага М13. Компоненты среды богаты азотом и ростовыми факторами, что позволяет размножать фаг в больших количествах без истощения клетки-хозяина.
Внешний вид светло-бежевый сыпучий гомогенный материал
Растворимость растворим в дистиллированной воде
Внешний вид 3,1%-ного раствора средне-янтарный
pH при 25°C 7,0
Примерный состав среды, г/л:
Казеиновый пептон (расщепленный ферментами поджелудочной железы), г/л 16
Дрожжевой экстракт, г/л 10
Хлорид натрия, г/л 5
Условия хранения в сухом месте при комнатной температуре
Скачать брошюру: Состав сред для исследовательских задач микробиологии и молекулярной генетики, брошюра, англ., 7 стр., 508 kB |
||||||||||||
|
|
||||||||||||
С помощью личного кабинета Вы сможете:
Сравнение